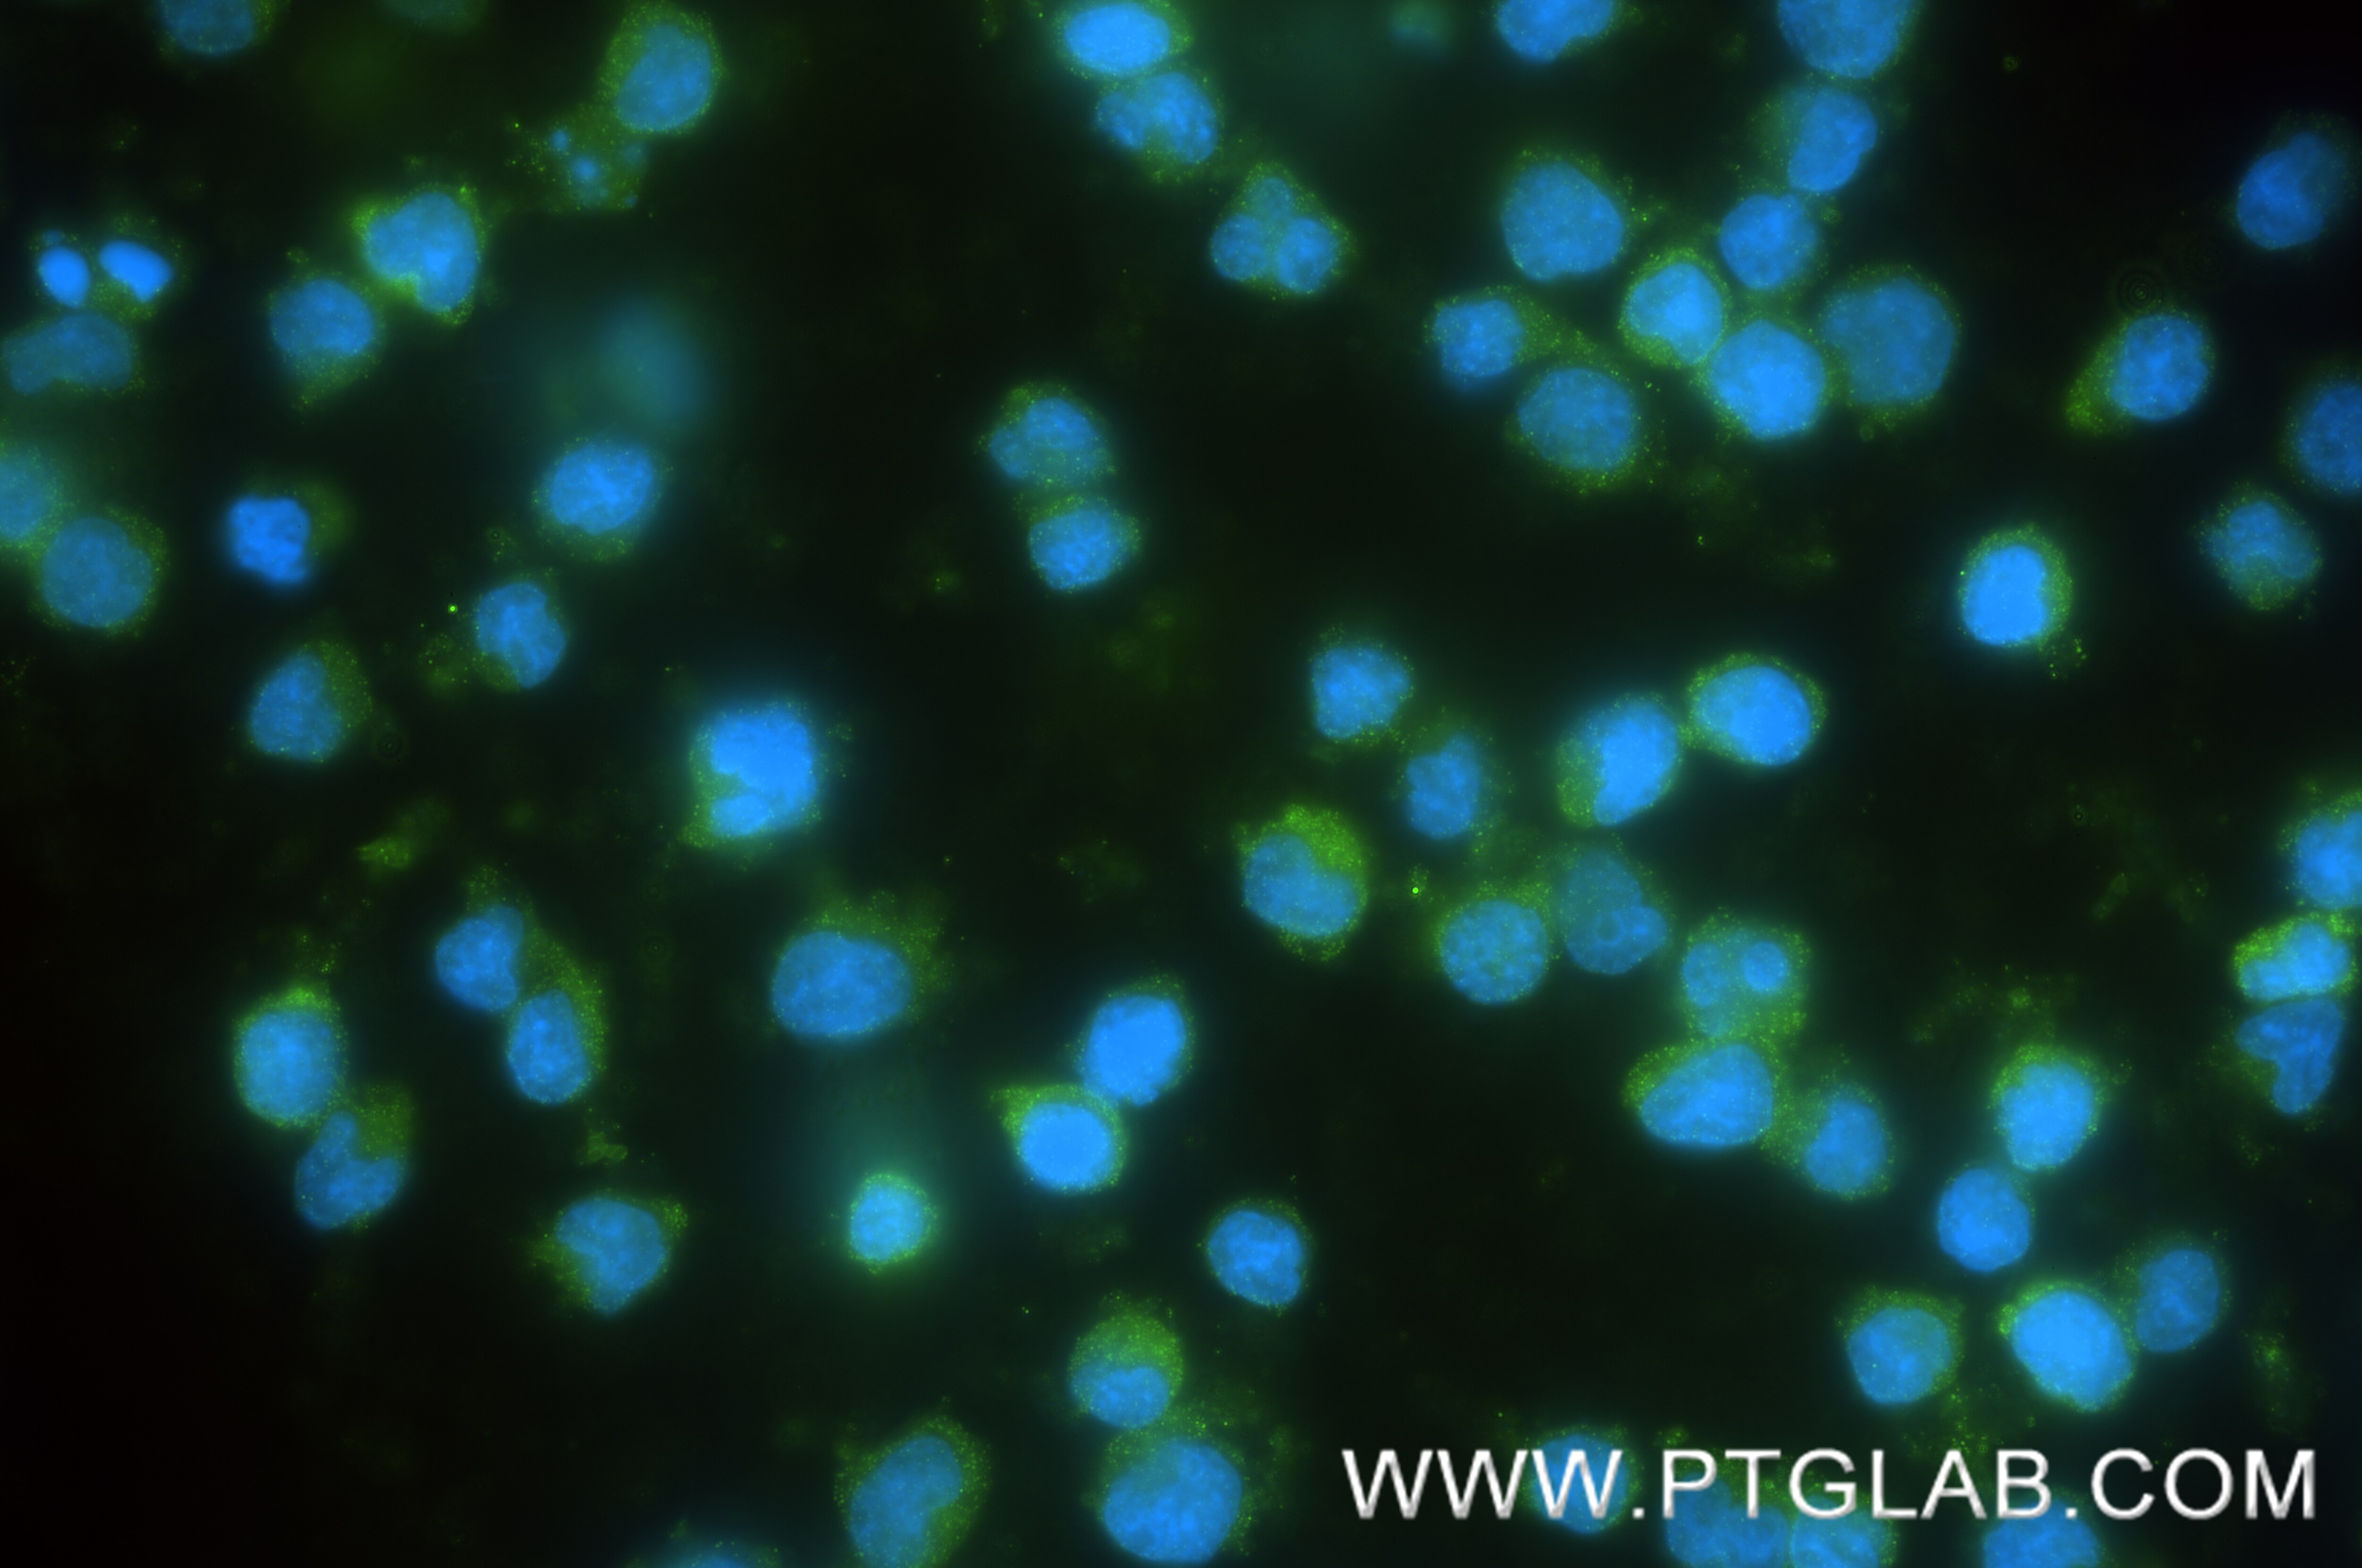
Immunofluorescence (IF) / fluorescent staining of Jurkat cells using IL-16 Recombinant monoclonal antibody (86927-2-RR)

Validation Data Gallery
Tested Applications
Recommended dilution
| Application | Dilution |
|---|---|
| It is recommended that this reagent should be titrated in each testing system to obtain optimal results. | |
Product Information
86927-2-PBS targets IL-16 as part of a matched antibody pair:
MP02772-1: 86927-2-PBS capture and 86927-1-PBS detection (validated in Cytometric bead array)
Unconjugated rabbit recombinant monoclonal antibody in PBS only (BSA and azide free) storage buffer at a concentration of 1 mg/mL, ready for conjugation. Created using Proteintech’s proprietary in-house recombinant technology. Recombinant production enables unrivalled batch-to-batch consistency, easy scale-up, and future security of supply.
This conjugation ready format makes antibodies ideal for use in many applications including: ELISAs, multiplex assays requiring matched pairs, mass cytometry, and multiplex imaging applications.Antibody use should be optimized by the end user for each application and assay.
| Tested Reactivity | human |
| Host / Isotype | Rabbit / IgG |
| Class | Recombinant |
| Type | Antibody |
| Immunogen |
CatNo: Eg4831 Product name: Recombinant Human IL-16 protein (rFc Tag) Source: mammalian cells-derived, pHZ-KIsec-N-rFc Tag: N-rFc Domain: 1-130 aa of AAC12732.1 Sequence: MPDLNSSTDSAASASAASDVSVESTAEATVCTVTLEKMSAGLGFSLEGGKGSLHGDKPLTINRIFKGAASEQSETVQPGDEILQLGGTAMQGLTRFEAWNIIKALPDGPVTIVIRRKSLQSKETTAAGDS 相同性解析による交差性が予測される生物種 |
| Full Name | interleukin 16 (lymphocyte chemoattractant factor) |
| Calculated molecular weight | 9 kDa |
| Observed molecular weight | 80 kDa |
| GenBank accession number | AAC12732.1 |
| Gene Symbol | IL-16 |
| Gene ID (NCBI) | 3603 |
| Conjugate | Unconjugated |
| Form | |
| Form | Liquid |
| Purification Method | Protein A purification |
| Storage Buffer | PBS only{{ptg:BufferTemp}}7.3 |
| Storage Conditions | Store at -80°C. |
Background Information
IL-16 is a pleiotropic cytokine that functions as a chemoattractant, a modulator of T cell activation, and an inhibitor of HIV replication. It is mainly produced by T lymphocytes but also by other immune cells, neuronal cells, fibroblasts and epithelial cells. The signaling process of this cytokine is mediated by CD4. IL-16 induces chemotaxis of CD4+ cells such as lymphocytes, eosinophils, and dendritic cells by ligating CD4 directly at a site distinct from other ligands. Among its multiple functions, IL-16 is a T cell chemoattractant involved in T helper cell inflammatory responses and the regulation of both T cell growth, and responsiveness to regulatory cytokines. The cytokine function is exclusively attributed to the secreted C-terminal peptide, while the N-terminal product may play a role in cell cycle control.